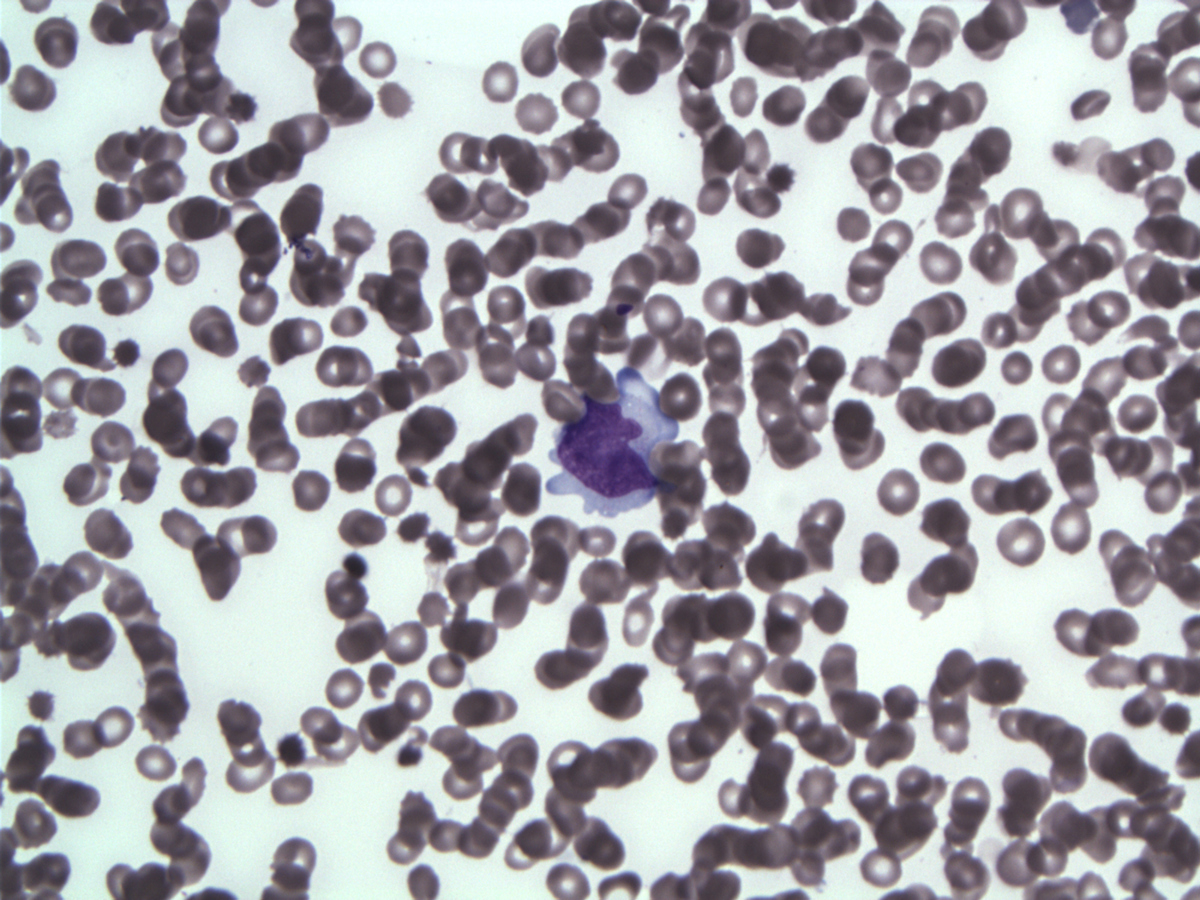
Lymphoma cell on WG-stained imprints

Institution: Roswell Park Cancer Institute
Additional authors:Sheila Sait, PhD
Session: Therapy-related myeloid neoplasms
HISTORY
69-year-old male presented to the ER in early December 2012 complaining of dizziness, coughing, shortness of breath, abdominal pain, cramping and diarrhea for 1-2 weeks. Clinical history included hypertension, coronary artery disease (recent bypass in August 2012), GI bleed, reflux, Sjogren syndrome, nephrectomy for carcinoma 6 years ago and knee surgery in February 2012.
He was admitted to ICU with a presumptive diagnosis of sepsis due to severe leukopenia and fever (40.5ºC). Endocarditis was ruled out and blood, urine, stool cultures and serology were negative for hepatitis A, B and C, Giardia, Cryptosporidium, C. difficile, bacteria, AFB and fungal organisms. CBC with pancytopenia. Patient continued to have high fever and a clinical working diagnosis of hemophagocytic syndrome (HPS) was rendered. Bone marrow biopsy was performed elsewhere (not available for review at the time of diagnosis) reportedly showing a hypocellular marrow, with no evidence of hemophagocytosis and a differential of low grade myelodysplastic syndrome vs myelotoxicity (inflammatory or metabolic). Patient was transferred to our hospital where pan-cultures were repeated (again negative) and marrow biopsy performed 8 days after the first sample. Laboratory results were remarkable for increased ALP, ALT, AST, LDH (6810), PT, ferritin (16,000), D-dimer (>20), hypofibrinogenemia ahd hypoalbuminemia. CBC showed pancytopenia: HGB 10.9, WBC 0.1, PLT 52. CT scan was compared to en earlier study and did not show any acute process or organomegaly but detected stable retroperitoneal and mediastinal lymphadenopathy, defined by the radiologist as increased number of normal-sized lymph nodes.DETAILS
The formalin-fixed, paraffin-embedded biopsy showed hypocellular marrow with markedly decreased granulocytic and erythroid precursors, dyspoietic megakaryocytes, extensive stromal injury and rare interstitial atypical cells, medium to large size, with ovoid nuclei variably condensed chromatin, occasional prominent large eosinophilic central nucleoli and abundant cytoplasm. Rare Reed-Sternberg–like cell were seen but no lymphoid aggregate or fibrosis was identified. In the touch imprints the atypical cells have large or medium-sized hyperchromatic nuclei and large central nucleoli, abundant basophilic cytoplasm with eosinophilic granules. Peripheral blood shows pancytopenia with severe neutropenia, rare Döhle bodies and no circulating tumor cells.
IMMUNOHISTOCHEMISTRY AND FLOW CYTOMETRY
By immunohistochemistry, tumor cells were positive for CD30 (strong, diffuse, membranous and Golgi pattern), CD3, CD7 (weak, subset), CD45, CD8 (small subset), Beta F1 (weak), EMA (subset), TIA-1, Granzyme B, perforin and negative for CD5, CD15, CD20, CD34, CD123, TDT, ALK1, PAX5, CD68, EBV-LMP and EBER. No lymphoid aggregate or sinusoidal pattern of involvement were seen. CD68-positive histiocytes were increased but only rare cells showed evidence of hemophagocytosis. FCM detected an abnormal population expressing CD2, CD3, CD7, CD8, CD30, CD45bright, CD45RA, CD45ROhet while negative for CD4, CD5, CD13, CD16, CD33, CD34, CD56 and CD57. Review and additional studies with the earlier biopsy revealed interval decreased cellularity and presence of CD30+ lymphoma cells in that sample
CYTOGENETIC FINDINGS
47,XY,+6[5]/46,XY[1].
FISH with ALK brekapart probe-no rearrangement in the few cells presentMOLECULAR FINDINGS
T cell gamma receptor clonal rearrangement by PCR; B cell clonality studies (IGH FR1-3 and IGK PCR) were negative.
INTERESTING FEATURES
1. Secondary hemophagocytic syndrome (SHPS) with rapid onset pancytopenia can clinically mimic acute leukemia.
2. Presumptive clinical diagnosis of HPS can be made even in absence of diagnostic histomorphologic features. 3. SHPS may resemble histologically a hypoplastic myelodysplastic syndrome when associated with cytokine-induced dyspoiesis, especially in the megakaryocytic lineage. 4. Despite increased marrow histiocytes, the hemophagocytic cells can be rare or absent late in the course of HPS, presumably due to marrow elements depletion. 5. The underlying T-cell lymphoma in SHPS can be subtle in the marrow sample requiring IHC and/or FCM for diagnosis. 6. Definitive classification is difficult in this case given the sCD3+CD8+CD30+CTX+EMA+/-CD56-EBER- phenotype but an ALK-ALCL interpretation was favored. Differential considerations include CD30+ PTCL and CD30+ enteropathy T cell lymphoma-both difficult if not impossible to exclude in the absence of tissue/nodal examination. Only approximately 7% of ALK-ALCL involve bone marrow (1) usually late in the course of the disease. Only rare case reports of ALK- ALCL with leukemic presentation exist (2-4) and ALK- ALCL with marrow involvement at presentation are extremely rare. Association with hemophagocytic syndrome as in this case has never been described with ALK protein testing.(5)Significance of trisomy 6 is unclear, either a pre-existent myelodysplastic syndrome but could represent tumor cells, recently described anomalies on this chromosome being reported in cutaneous ALCL. (6)1. Savage KJ et al. Blood 2008;111: 5496-55042. Lu Y et al Leuk Res. 2010 ;34:475-823. Tanaka H et al. Intern Med. 2012;51:199-2034. Wong WS et al. Leuk Lymphoma. 2010;51:1927-305. Wong KF et al. Am J Hematol. 1991;37:112-9\6. Pham-Ledard A et al. J Invest Dermatol. 2010;130:816-25PROPOSED DIAGNOSIS
CD30-positive T-cell lymphoma involving marrow at presentation with hemophagocytic syndrome, favor ALK- ALCL
CONSENSUS DIAGNOSIS
CD30-positive T-cell lymphoma with hemophagocytic syndrome
| Bone marrow at presentation-day 1 |  |
| Bone marrow day 9 |  |
| Hypocellular marrow space with stromal injury |  |
| Stromal hemorrhage and fibrin and hyperchromatic megakaryocytes |  |
| Large atypical lymphoma cells with abnormal mitoses |  |
| Scattered lymphoma cells with cellular debris |  |
| Medium-sized lymphoma cells |  |
| Lymphoma cell on WG-stained imprints |  |
| Lymphoma cell on WG-stained imprints | |
| CD3 |  |
| CD30 |  |
| CD30 labels the neoplastic cells with membranous and Golgi pattern |  |
| Granzyme B |  |
| Perforin |  |
| EMA |  |
| EMA labels few medium and large cells |  |
| Flow cytometry -neoplastic cells painted blue |  |
| Flow cytometry -neoplastic cells painted green/yellow |  |
| Flow cytometry -neoplastic cells painted red |  |
| Flow cytometry -neoplastic cells painted light blue (upper panels ) and red (lower panels) |  |